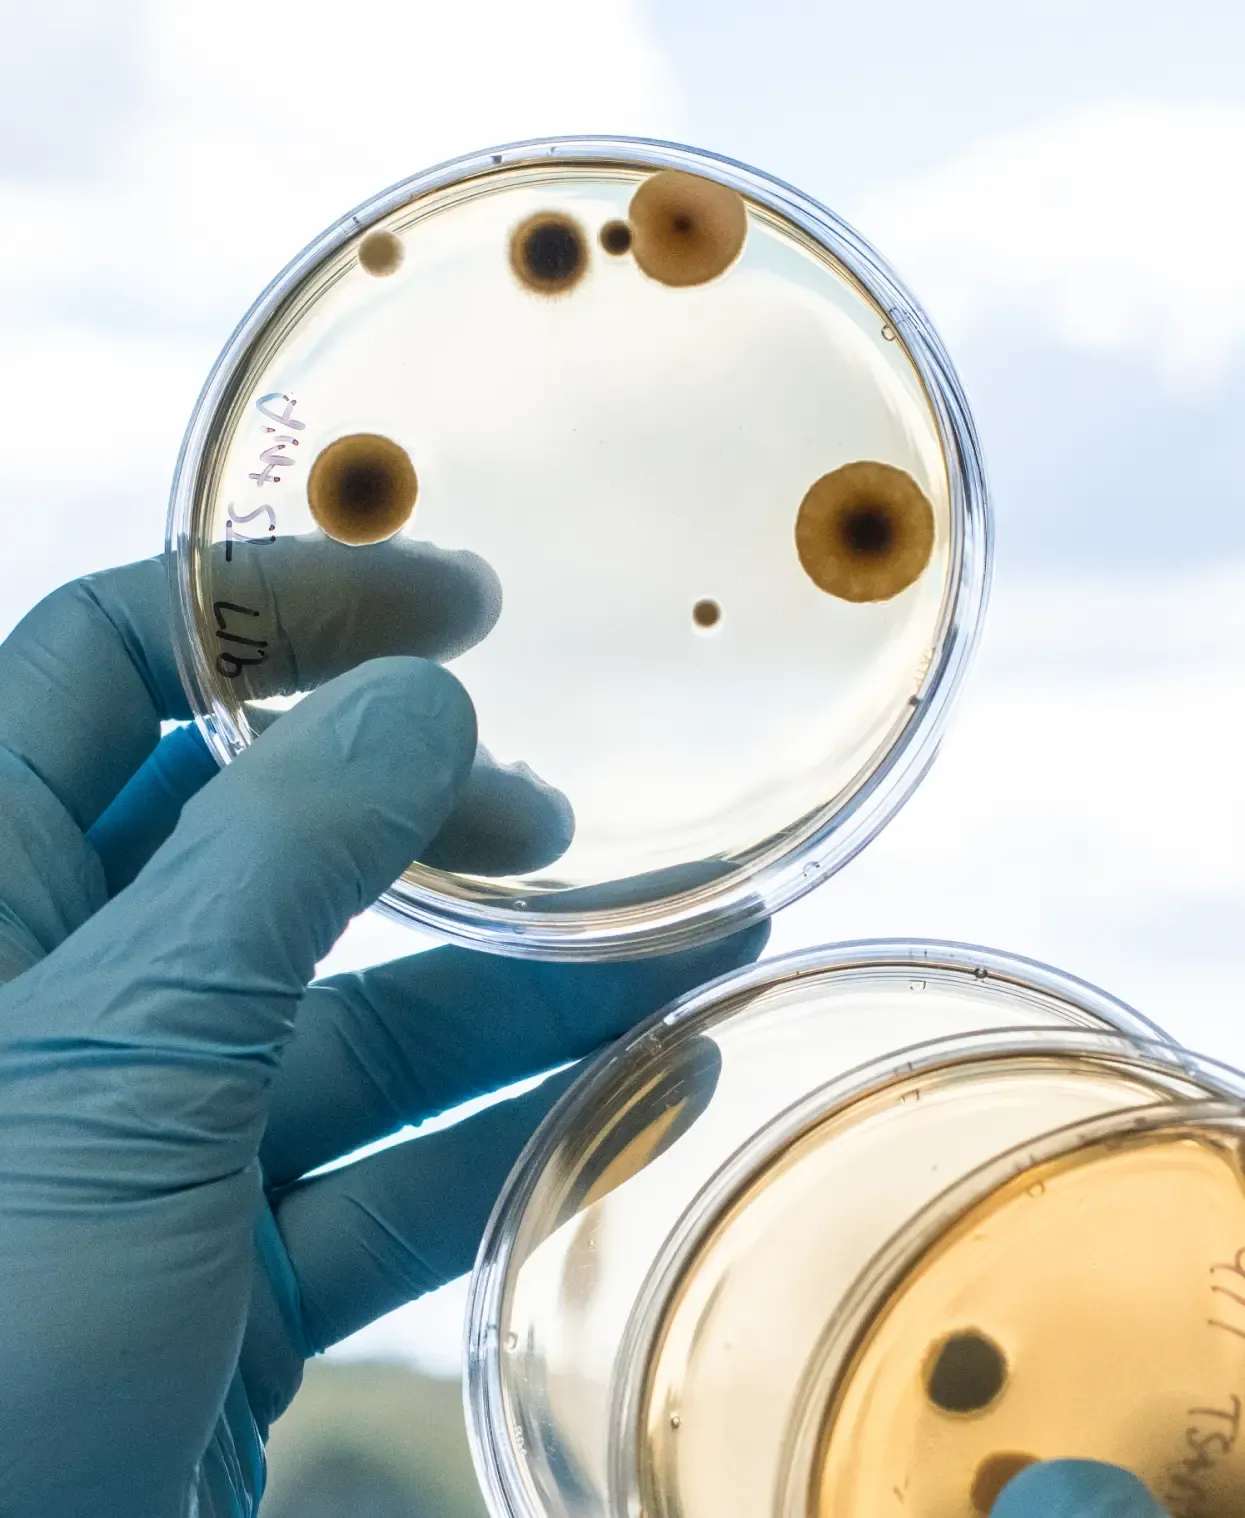
Turning science into substance

Where NutritionMeets Humanity




TurtleTree is ushering in a new era of sustainable nutrition that is transforming food and beverage
Trailblazing with one of the most valuable ingredients in milk, TurtleTree has released LF+®
LF+® is the world's first sustainably-produced lactoferrin made using precision fermentation technology

It all began with cheese
In her quest to find top-quality milk for her cheesemaking passion, co-founder Fengru discovered distressing farming conditions and the excessive use of hormones and antibiotics in cows. This led her to believe that there must be a healthier and more sustainable approach to milk production.

The start of TurtleTree
Two entrepreneurs united by a shared vision to revolutionize how the world produces and consumes dairy nutrition.
Turning science into substance
Years of rigorous R&D transformed breakthrough cellular technology into a scalable precision fermentation platform.

Lactoferrin is first
We identified lactoferrin — milk's most valuable protein — as our first product, addressing a massive global supply gap.

This is just the beginning
With LF+ now a reality, we're expanding our platform to unlock more of nature's most powerful bioactive ingredients.












